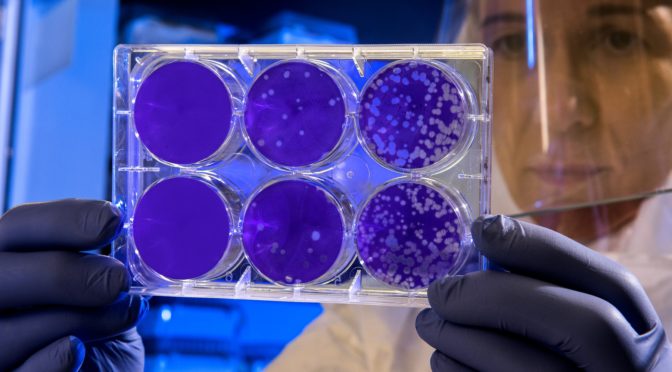
Using faceshields

FLORENCE, ITALY – In an opinion published in the scientific journal Jama by US scholars, the effectiveness of face shields in contrasting the spread of the epidemic from Covid-19 is mentioned.
Recalling how the US Centers for Disease Control and Prevention (CDC) have recommended that all people wear a fabric mask in public to control the spread of the virus, they express the belief that face shields (transparent Plexiglas visors or otherwise) may represent a better choice.
Beyond the opinion of the researchers, the data disclosed and some considerations are interesting. If you have to use Covid19-protection per for weeks or months, face shield are cheeper and more ecological.
They can be produced and distributed quickly: they do not require special materials for manufacturing, as the meltblown for the masks.
While surgical masks have a limited duration and little possibility of being recycled, the face shields can be reused indefinitely and can be easily cleaned with water and soap or common household disinfectants.
They are easy to regulate and comfortable to wear even with eyeglasses, protect the airways and prevent the wearer from touching their face. The people who wear them do not have to take them off to speak: they remind the interlocutors of the need for social distancing but allow you to see facial expressions and lip movements.
Numerous companies in US (and also in Italy) are using the face shield. You can see even wore by shop assistants and cashiers in supermarkets. The government of Japan decided to use face shields in schools for alumnus and professors.
For optimal protection, the visor should extend under the chin anteriorly, up to the ears laterally and there should be no exposed space between the forehead and the beginning of the barrier. It’s easy to find face shields at less than 20 euros on the more common marketplaces.

Discover more from Florence Daily News
Subscribe to get the latest posts sent to your email.

Face shield is one option to protect us from corona virus and nowadays become a fashion.